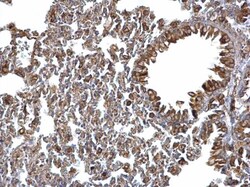
Invitrogen ERp57 Polyclonal Antibody 100 &mu;L; Unconjugated:Antibodies,

missing translation for 'onlineSavingsMsg'
Learn More
Learn More
Invitrogen™ ERp57 Polyclonal Antibody


Description
Keep as concentrated solution. Predicted reactivity: Mouse (100%), Rat (100%), Pig (100%), Sheep (100%), Rhesus Monkey (100%), Chimpanzee (100%), Bovine (100%). Positive Control: H1299, HeLa, HepG2, NIH-3T3, JC, BCL-1, rat liver. Store product as a concentrated solution. Centrifuge briefly prior to opening the vial.
This gene encodes a protein of the endoplasmic reticulum that interacts with lectin chaperones calreticulin and calnexin to modulate folding of newly synthesized glycoproteins. The protein was once thought to be a phospholipase; however, it has been demonstrated that the protein actually has protein disulfide isomerase activity. It is thought that complexes of lectins and this protein mediate protein folding by promoting formation of disulfide bonds in their glycoprotein substrates.

Specifications
Specifications
| Antigen | ERp57 |
| Applications | Immunohistochemistry (Paraffin), Western Blot, Immunocytochemistry |
| Classification | Polyclonal |
| Concentration | 1 mg/mL |
| Conjugate | Unconjugated |
| Formulation | PBS with 20% glycerol and 0.01% thimerosal; pH 7 |
| Gene | PDIA3 |
| Gene Accession No. | P11598, P27773, P30101 |
| Gene Alias | 58 kDa glucose-regulated protein; 58 kDa microsomal protein; 58kDa; Disulfide isomerase ER-60; endoplasmic reticulum P58; endoplasmic reticulum protein; endoplasmic reticulum resident protein 57; Endoplasmic reticulum resident protein 60; epididymis secretory protein Li 269; epididymis secretory sperm binding protein Li 93n; ER p57; ER protein 57; ER protein 60; ER60; ER-60 protease; Erp; ERp 57; ERp57; ERP57 protein; ERP60; ERp61; glucose regulated protein 58; glucose regulated protein 58kD; glucose regulated protein, 58 kDa; glucose regulated protein, 58kDa; GRP 57; GRP 58; GRP57; Grp58; grp-58; HEL-S-269; HEL-S-93n; HIP-70; HsT17083; I79_003765; oxidoreductase ERp57; p58; PDI; PDIA 3; PDIA3; PDI-Q2; phospholipase C, alpha; phospholipase C-alpha; PI PLC; PI-PLC; PLC alpha; PLC[a]; Plca; protein disulfide isomerase associated 3; protein disulfide isomerase family A member 3; protein disulfide isomerase family A, member 3; protein disulfide isomerase-associated 3; protein disulfide-isomerase A3; Q-2 |
| Gene Symbols | PDIA3 |
| Show More |
Product Title
By clicking Submit, you acknowledge that you may be contacted by Fisher Scientific in regards to the feedback you have provided in this form. We will not share your information for any other purposes. All contact information provided shall also be maintained in accordance with our Privacy Policy.
Spot an opportunity for improvement?